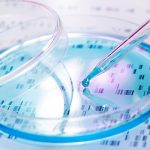
New genetic test to predict chances of serious concussion New genetic test to predict chances of serious concussion

Migraine surgery linked to improved symptoms in adolescents
Migraines in adolescents are common and often not sufficiently controlled. Migraine headache prevalence among all pediatric patients is estimated at nearly eight percent. Previous...
Infections in contact-lens wearers linked to changes in eye bacteria
A new study suggests that people who wear contact lenses may be more prone to eye infections than people who do not wear them...
Obesogens are an environmental link to obesity
More than one-third of Americans are obese, according the Centers for Disease Control and Prevention. It’s a well-known fact that sedentary lifestyles and poor...
New genetic test to predict chances of serious concussion
It has been some 20 years since the ties between Alzheimer's disease and a patient's genes were first discovered. Researchers are now exploring genetic...
Tinnitus brain mapping may lead to more effective treatment
Tinnitus is the sound of ringing, roaring, buzzing, hissing, or clicking that occurs inside the head. According to the American Tinnitus Association, currently, more...
Pets may pose a risk to kids with compromised immune systems
Although pets can be the source of love, companionship and emotional support, they can also be the source of disease and infection, according to...
Endovascular therapy for stroke sufferers
For its capacity to lessen the frequency of incapacity, a strategy called endovascular therapy (ET) could be the best choice for some stroke sufferers,...
Repair damaged nerves in multiple sclerosis by stimulating body’s own stem cells
A recent study found two drugs that can activate stem cells in the brain and reduce disease severity in animal models of multiple sclerosis....
Researchers kill prostate cancer cells with copper
Researchers have recently discovered a way to kill prostate cancer cells with copper. A team of scientists and researchers at Duke Medicine combined copper...
Eating eggs can reduce the risk of diabetes
In the event that you love eggs, there is uplifting news for you. Egg utilization could decrease the danger of Type-2 diabetes, says another...
Top News
Hey ISIS, You Suck: Local Muslims Post Anti-ISIS Billboard
A new billboard on Manchester Road in Missouri reads, "HEY ISIS, YOU SUCK!!! From: #ActualMuslims."
A group of Muslim-Americans have put up a blunt billboard...